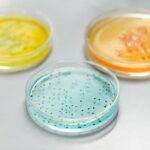
Close-up of colorful petri dishes used in a laboratory for scientific experiments.

Beschreibung
Miliartuberkulose ist eine seltene und schwere Form der Tuberkulose (TB), die mehrere Organe und Systeme im Körper befällt. Sie tritt auf, wenn sich Mycobacterium tuberculosis, das Bakterium, das TB verursacht, über den Blutkreislauf ausbreitet und in verschiedene Organe gelangt, wo es zur Bildung winziger Granulome führt. Diese Granulome können die Lunge, die Leber, die Milz, die Nieren, die Knochen, das Gehirn und andere Organe befallen und eine Vielzahl von Symptomen und Komplikationen verursachen.
Miliare Tuberkulose ist relativ selten, kann jedoch sowohl bei Erwachsenen als auch bei Kindern auftreten, insbesondere bei Personen mit geschwächtem Immunsystem. Die Prävalenz der miliaren Tuberkulose variiert je nach Region, wobei höhere Raten in Gebieten zu verzeichnen sind, in denen TB endemisch ist, sowie bei immungeschwächten Bevölkerungsgruppen.
Die Miliartuberkulose kann aufgrund ihrer weitreichenden Ausbreitung im gesamten Körper zu schweren Komplikationen führen. Zu diesen Komplikationen können Organfunktionsstörungen, Atemversagen, Beteiligung des Zentralnervensystems (z. B. Meningitis), Knochen- und Gelenkprobleme, gastrointestinale Komplikationen und sogar der Tod gehören, wenn sie nicht rechtzeitig diagnostiziert und behandelt wird.
Die Diagnose einer Miliartuberkulose erfordert eine Kombination aus klinischem Verdacht, radiologischen Befunden und Labortests. Bildgebende Untersuchungen wie Röntgenaufnahmen oder CT-Scans des Brustkorbs können charakteristische Muster von Miliarknoten in der Lunge und anderen betroffenen Organen aufzeigen. Labortests, darunter Sputum- oder Gewebekulturen, Säure-Färbung und molekulare Techniken wie PCR, werden eingesetzt, um das Vorhandensein von Mycobacterium tuberculosis zu bestätigen. Eine sofortige Einleitung der Behandlung ist entscheidend und umfasst in der Regel eine Kombination mehrerer Anti-TB-Medikamente über einen längeren Zeitraum.
Die Miliartuberkulose wird durch das Bakterium Mycobacterium tuberculosis verursacht, das durch Tröpfcheninfektion von einer infizierten Person übertragen wird. Zu den Faktoren, die das Risiko einer Miliartuberkulose erhöhen, gehören Immunschwächezustände wie HIV/AIDS, Unterernährung, Diabetes, Krebs, längere Kortikosteroid-Einnahme und andere Erkrankungen, die das Immunsystem schwächen.
Die Prävention der Miliartuberkulose umfasst verschiedene Maßnahmen, die darauf abzielen, die Gesamtbelastung durch Tuberkulose zu verringern und das Infektionsrisiko zu minimieren. Dazu gehören die Umsetzung wirksamer TB-Kontrollprogramme, die frühzeitige Diagnose und Behandlung von Lungen-TB-Fällen, die Kontaktverfolgung und das Screening auf latente TB-Infektionen, Impfungen (z. B. Bacille Calmette-Guérin) sowie die Förderung allgemeiner Maßnahmen wie gute Atemhygiene, angemessene Belüftung und Infektionskontrollmaßnahmen.
Die biologischen Hintergründe
Die Miliartuberkulose befällt aufgrund der hämatogenen Ausbreitung von Mycobacterium tuberculosis mehrere Organe und Systeme im Körper. Normalerweise sorgen diese Organe und Systeme für die Aufrechterhaltung der Homöostase und unterstützen verschiedene Körperfunktionen.
Die Lunge, einer der Hauptorte, die von der Miliartuberkulose betroffen sind, ist für den Sauerstoffaustausch verantwortlich. In einem gesunden Zustand verfügen die Lungen über ein komplexes Netzwerk aus Atemwegen und Alveolen, die den Transfer von Sauerstoff aus der eingeatmeten Luft in den Blutkreislauf erleichtern. Bei der Miliartuberkulose beeinträchtigen jedoch winzige Granulome in den Lungen diesen Prozess. Die Granulome, die aus Immunzellen und infizierten Makrophagen bestehen, können die Lungenfunktion beeinträchtigen und zu Atemwegsbeschwerden wie Husten, Atemnot und Brustbeschwerden führen.
Da sich die Miliartuberkulose über den Blutkreislauf ausbreitet, kann sie andere Organe wie Leber, Milz, Nieren, Knochen, Gehirn und weitere Organe befallen. Diese Organe unterstützen normalerweise verschiedene physiologische Prozesse. Die Leber übernimmt beispielsweise wichtige Stoffwechselfunktionen, die Entgiftung und die Produktion lebenswichtiger Proteine. Die Milz ist an der Filterung des Blutes und der Unterstützung des Immunsystems beteiligt. Die Nieren spielen eine entscheidende Rolle bei der Filterung von Abfallprodukten und der Aufrechterhaltung des Flüssigkeits- und Elektrolythaushalts. Wenn diese Organe von einer Miliartuberkulose befallen sind, kann es zu Entzündungen, Schäden an den Gewebestrukturen und Störungen ihrer normalen Funktionen kommen.
Das Vorhandensein von Granulomen in verschiedenen Organen kann deren normale Funktion stören und ihre strukturelle Integrität beeinträchtigen. Entzündungen und Gewebeschäden, die durch die Immunreaktion auf die Infektion mit Mycobacterium tuberculosis verursacht werden, können zu Organfunktionsstörungen und möglicherweise schweren Komplikationen führen. Die weitreichende Beteiligung mehrerer Organe kann je nach den betroffenen Organen zu einer Vielzahl von Symptomen führen und die allgemeine Gesundheit und das Wohlbefinden erheblich beeinträchtigen.
Arten und Symptome
Die Miliartuberkulose kann in verschiedenen Formen auftreten und verschiedene Organe und Systeme im Körper befallen. Die Krankheit wird in der Regel anhand der primär betroffenen Organe in verschiedene Arten unterteilt. Jede Art weist einzigartige Symptome und unterschiedliche Merkmale auf, die sich auf das klinische Erscheinungsbild auswirken.
Pulmonale Miliartuberkulose:
Die pulmonale Miliartuberkulose betrifft in erster Linie die Lunge. Sie ist durch eine weitreichende Ausbreitung von Mycobacterium tuberculosis im Lungengewebe gekennzeichnet. Zu den Symptomen können anhaltender Husten, Brustschmerzen, Atemnot, Müdigkeit und Fieber gehören. Röntgenaufnahmen oder CT-Scans des Brustkorbs können mehrere winzige Knötchen oder „Millet-Samen”-ähnliche Erscheinungen in der gesamten Lunge zeigen.
Extrapulmonale Miliartuberkulose:
Die extrapulmonale Miliartuberkulose bezeichnet die Ausbreitung von Mycobacterium tuberculosis über die Lunge hinaus auf mehrere Organe. Die spezifischen Symptome und betroffenen Stellen variieren je nach den betroffenen Organen. Häufige Stellen sind die Leber, die Milz, die Nieren, die Knochen, das zentrale Nervensystem und die Lymphknoten. Zu den Symptomen können organspezifische Manifestationen wie Hepatomegalie (Lebervergrößerung), Splenomegalie (Milzvergrößerung), Knochenschmerzen, neurologische Ausfälle und Lymphadenopathie (Lymphknotenvergrößerung) gehören.
Komplikationen:
Die Miliartuberkulose kann zu verschiedenen Komplikationen führen, die schwerwiegend und lebensbedrohlich sein können. Zu den möglichen Komplikationen gehören:
● Organfunktionsstörungen: Die weitreichende Ausbreitung von Mycobacterium tuberculosis kann je nach betroffenen Stellen zu Organfunktionsstörungen in den betroffenen Organen führen, wie z. B. Leberfunktionsstörungen, Nierenfunktionsstörungen oder neurologischen Ausfällen.
● Atemversagen: In schweren Fällen kann die miliaire Tuberkulose der Lunge aufgrund einer ausgedehnten Lungenbeteiligung und einer beeinträchtigten Lungenfunktion zu einem Atemversagen führen.
● Meningitis: Eine Beteiligung des Zentralnervensystems kann zu einer tuberkulösen Meningitis führen, die Symptome wie Kopfschmerzen, Nackensteifigkeit, Bewusstseinsstörungen und neurologische Ausfälle verursacht.
● Komplikationen an Knochen und Gelenken: Tuberkulose kann Knochen und Gelenke befallen und zu Osteomyelitis (Knochenentzündung), Gelenkzerstörung und Deformitäten führen.
● Disseminierte Infektion: Ohne eine sofortige und wirksame Behandlung kann die Miliartuberkulose schnell fortschreiten und sich weiter ausbreiten, was zu einer systemischen Infektion führen kann, die lebensbedrohlich sein kann.
Es ist wichtig zu beachten, dass eine frühzeitige Erkennung, eine genaue Diagnose und eine angemessene Behandlung entscheidend sind, um Komplikationen zu vermeiden und die Ergebnisse für Personen mit Miliartuberkulose zu verbessern.
Untersuchung und Diagnostik
Eine genaue und rechtzeitige Diagnose der Miliartuberkulose ist für eine wirksame Behandlung und Therapie der Erkrankung von entscheidender Bedeutung. Dieser Abschnitt bietet einen Überblick über die diagnostischen Ansätze, die bei der Beurteilung von Verdachtsfällen auf Miliartuberkulose verwendet werden.
Klinische Untersuchung:
Die klinische Untersuchung spielt eine wichtige Rolle bei der Erstuntersuchung von Personen, bei denen der Verdacht auf Miliartuberkulose besteht. Sie umfasst in der Regel eine umfassende Anamnese und körperliche Untersuchung. Die Anamnese dient dazu, Informationen über Symptome, Dauer, Tuberkuloseexposition und relevante Erkrankungen zu sammeln. Während der körperlichen Untersuchung untersuchen die Ärzte sorgfältig verschiedene Organsysteme, um Anzeichen einer systemischen Beteiligung zu erkennen, wie z. B. vergrößerte Lymphknoten, Hepatosplenomegalie oder neurologische Ausfälle.
Laboruntersuchungen und Bildgebung:
Laboruntersuchungen und bildgebende Verfahren sind für die Diagnose einer Miliartuberkulose unerlässlich. Die folgenden diagnostischen Verfahren werden verwendet:
● Großes Blutbild (CBC): Es können erhöhte Werte der weißen Blutkörperchen, Anämie oder Thrombozytopenie vorliegen.
● Erythrozytensedimentationsrate (ESR) und C-reaktives Protein (CRP): Erhöhte Werte deuten auf eine Entzündung hin.
● Tuberkulin-Hauttest oder Interferon-Gamma-Release-Assay (IGRA): Diese Tests beurteilen die Immunantwort einer Person auf Mycobacterium tuberculosis. Positive Ergebnisse deuten auf eine Exposition gegenüber Tuberkulose hin, unterscheiden jedoch nicht zwischen aktiver und latenter Infektion.
● Sputumanalyse: Eine mikroskopische Untersuchung und Kultur von Sputumproben kann durchgeführt werden, um säurefeste Bazillen (AFB) nachzuweisen und das Vorhandensein von Mycobacterium tuberculosis zu bestätigen. Aufgrund der disseminierten Natur der Miliartuberkulose liefern Sputumproben jedoch nicht immer positive Ergebnisse.
● Röntgenaufnahme des Brustkorbs: Obwohl diese Untersuchung nicht spezifisch für die Miliartuberkulose ist, kann sie charakteristische Befunde wie multiple kleine Knötchen, die über die Lunge verstreut sind, aufzeigen.
● Computertomographie (CT): Bietet eine detailliertere Beurteilung der Lungenbeteiligung sowie eine Beurteilung extrapulmonaler Stellen.
● Ultraschalluntersuchung oder CT des Abdomens: Nützlich zur Beurteilung von Hepatosplenomegalie und Lymphknotenvergrößerung.
● Biopsie: Bei Verdacht auf eine extrapulmonale Beteiligung kann eine Biopsie des betroffenen Organs erforderlich sein, um das Vorhandensein von Mycobacterium tuberculosis zu bestätigen.
Therapie und Behandlungen
Die Behandlung der Miliartuberkulose umfasst eine umfassende und medikamentöse Therapie, die darauf abzielt, die Infektion zu beseitigen, das Fortschreiten der Krankheit zu kontrollieren und Komplikationen vorzubeugen. Der therapeutische Ansatz umfasst häufig eine Kombination aus Tuberkulose-Medikamenten und unterstützenden Maßnahmen.
Medikamente gegen Tuberkulose:
Der Grundpfeiler der Behandlung der Miliartuberkulose ist der Einsatz von Medikamenten gegen Tuberkulose. Die wichtigsten Medikamente sind Isoniazid (INH), Rifampin (RIF), Pyrazinamid (PZA) und Ethambutol (EMB). Diese Medikamente werden in der Regel in Kombination verabreicht und wirken synergistisch, um die Mycobacterium tuberculosis-Bakterien zu bekämpfen und die Entwicklung von Arzneimittelresistenzen zu verhindern.
Behandlungsschema:
Das Behandlungsschema für die Miliartuberkulose besteht aus einer anfänglichen Intensivphase, gefolgt von einer Fortsetzungsphase. Während der Intensivphase, die zwei Monate dauert, wird den Patienten eine Kombination aus Isoniazid, Rifampin, Pyrazinamid und Ethambutol verschrieben. Das Ziel ist es, die Mycobacterium tuberculosis-Bakterien schnell zu unterdrücken und die Bakterienlast zu reduzieren. Nach der Intensivphase beginnt die Fortsetzungsphase, die vier bis sieben Monate dauert und in der die Patienten weiterhin Isoniazid und Rifampin einnehmen. Die Fortsetzungsphase konzentriert sich auf die Beseitigung aller verbleibenden Bakterien und die Verhinderung eines Rückfalls.
Unterstützende Behandlung:
Neben den Medikamenten gegen Tuberkulose spielt die unterstützende Behandlung eine wichtige Rolle bei der Behandlung der Miliartuberkulose. Eine ausreichende Ernährung und Flüssigkeitszufuhr sind wichtig für die allgemeine Gesundheit und zur Unterstützung der Immunantwort des Körpers. Die Behandlung der Symptome, beispielsweise durch die Gabe von Antipyretika zur Fiebersenkung, trägt zur Verbesserung des Wohlbefindens des Patienten bei. Die regelmäßige Überwachung des klinischen Zustands, der Laborparameter und der Medikamenteneinnahme des Patienten ist während der Behandlung von entscheidender Bedeutung. Röntgenaufnahmen des Brustkorbs, Sputumanalysen und andere diagnostische Tests können wiederholt werden, um das Ansprechen auf die Behandlung zu beurteilen und den Krankheitsverlauf zu bewerten.
Besondere Überlegungen:
In einigen Fällen, z. B. bei medikamentenresistenter Miliartuberkulose oder wenn der Patient Begleiterkrankungen hat, können individuelle Behandlungsansätze erforderlich sein. Bei komplexen Fällen wird die Konsultation von Spezialisten für Infektionskrankheiten oder Tuberkulose-Experten empfohlen. Die Dauer und Intensität der Behandlung kann je nach Ansprechen des Patienten und den spezifischen Umständen angepasst werden.
Einhaltung der Behandlung:
Es ist von größter Bedeutung, dass Patienten die gesamte Behandlung wie verschrieben absolvieren, auch wenn sie sich bereits besser fühlen. Ein vorzeitiger Abbruch der Therapie kann zu einem Behandlungsversagen, einem Rückfall oder der Entwicklung resistenter Stämme führen. Gesundheitsdienstleister spielen eine entscheidende Rolle bei der Aufklärung und Unterstützung der Patienten, um die Einhaltung des Behandlungsplans sicherzustellen.
Ursachen und Risikofaktoren
Die Miliartuberkulose wird durch eine Infektion mit dem Bakterium Mycobacterium tuberculosis verursacht. Die Bakterien gelangen in erster Linie durch das Einatmen infizierter Atemtröpfchen, die von Personen mit aktiver Lungentuberkulose ausgestoßen werden, in den Körper. Das Verständnis der Ursachen und Risikofaktoren dieser Krankheit ist für ihre Prävention und Behandlung von entscheidender Bedeutung.
Ursachen:
Die direkte Ursache der Miliartuberkulose ist die Infektion mit Mycobacterium tuberculosis. Beim Einatmen gelangen die Bakterien in die Lunge und dringen in die Alveolen ein, wo sie von Makrophagen, einer Art von Immunzellen, verschlungen werden. In einigen Fällen können die Bakterien jedoch der Zerstörung durch das Immunsystem entgehen und sich über die Blutbahn auf andere Organe ausbreiten. Die Bakterien können mehrere Organe gleichzeitig befallen, was zu dem charakteristischen milzförmigen Muster führt, das in bildgebenden Untersuchungen zu sehen ist. Die Ausbreitung wird durch die Fähigkeit der Bakterien erleichtert, innerhalb der Makrophagen zu überleben und sich zu vermehren, wodurch sie sich im gesamten Körper ausbreiten können.
Risikofaktoren:
Mehrere Faktoren können das Risiko für die Entwicklung einer Miliartuberkulose erhöhen. Dazu gehören:
● Immunschwäche: Personen mit geschwächtem Immunsystem, wie z. B. HIV/AIDS-Patienten, Empfänger von Organtransplantaten oder Personen, die eine immunsuppressive Therapie erhalten, sind anfälliger für die Entwicklung einer Miliartuberkulose.
● Alter: Säuglinge und Kleinkinder sowie ältere Erwachsene haben ein erhöhtes Risiko, an schweren Formen der Tuberkulose, einschließlich Miliartuberkulose, zu erkranken.
● Mangelernährung: Schlechte Ernährung und zugrunde liegende Mangelernährung schwächen das Immunsystem und machen Menschen anfälliger für Tuberkuloseinfektionen, einschließlich Miliartuberkulose.
● Beengte Lebensverhältnisse: Enger und längerer Kontakt mit Personen mit aktiver Tuberkulose, insbesondere in beengten Verhältnissen wie Gefängnissen oder Obdachlosenunterkünften, erhöht das Risiko einer Übertragung und der anschließenden Entwicklung einer Miliartuberkulose.
● Reisen in Endemiegebiete: Reisen oder Aufenthalte in Regionen mit einer hohen Tuberkuloseprävalenz erhöhen das Risiko einer Exposition gegenüber Mycobacterium tuberculosis und der anschließenden Entwicklung einer Miliartuberkulose.
● Schlecht behandelte Lungentuberkulose: Eine unzureichende oder verzögerte Behandlung einer aktiven Lungentuberkulose kann zum Fortschreiten der Erkrankung bis hin zur Miliartuberkulose führen.
● Arzneimittelresistenz: In Regionen mit einer hohen Prävalenz von arzneimittelresistenter Tuberkulose besteht für Personen, die mit arzneimittelresistenten Stämmen infiziert sind, ein erhöhtes Risiko, an Miliartuberkulose zu erkranken, wenn die Infektion nicht angemessen behandelt wird.
Es ist wichtig zu beachten, dass bestimmte Risikofaktoren zwar die Wahrscheinlichkeit einer Miliartuberkulose erhöhen, aber nicht alle Personen mit diesen Risikofaktoren die Krankheit entwickeln. Darüber hinaus können auch Personen ohne offensichtliche Risikofaktoren von Miliartuberkulose betroffen sein, wenn sie mit Personen mit aktiver Tuberkulose in Kontakt kommen.
Krankheitsverlauf und Prognose
Das Verständnis des Verlaufs der Miliartuberkulose und ihrer Prognose ist für eine wirksame Behandlung und Patientenversorgung von entscheidender Bedeutung. Dieser Abschnitt bietet einen Überblick über den typischen Verlauf der Krankheit, die einzelnen Stadien und den allgemeinen Zeitrahmen der Progression. Darüber hinaus wird die Prognose der Miliartuberkulose unter Berücksichtigung verschiedener Faktoren, die das Ergebnis beeinflussen können, erörtert.
Krankheitsverlauf:
Die Miliartuberkulose verläuft unterschiedlich, da sich die Infektion im gesamten Körper ausbreitet. Nach der ersten Inhalation von Mycobacterium tuberculosis gelangen die Bakterien in die Lunge und vermehren sich in den Alveolen. Von dort gelangen sie in den Blutkreislauf und können sich so auf mehrere Organe ausbreiten, darunter Leber, Milz, Nieren, Knochenmark und Gehirn. Die Ausbreitung erfolgt auf hämatogenem Wege, was zu dem charakteristischen Miliarmuster führt, das in bildgebenden Untersuchungen zu beobachten ist, bei dem winzige, milletähnliche Knötchen über die betroffenen Organe verstreut sind.
Das Fortschreiten der Miliartuberkulose lässt sich in mehrere Stadien unterteilen:
● Primärinfektion: Die Erstinfektion erfolgt in der Lunge, wenn die Bakterien eingeatmet werden. In einigen Fällen kontrolliert das Immunsystem die Infektion wirksam, was zu einer latenten Tuberkulose führt. In anderen Fällen können die Bakterien jedoch die Abwehrmechanismen der Lunge umgehen und sich über den Blutkreislauf auf verschiedene Organe ausbreiten.
● Ausbreitung: Sobald die Bakterien in den Blutkreislauf gelangen, verbreiten sie sich auf verschiedene Organe, was zu einer weitreichenden Beteiligung führt. Dieses Stadium ist durch die Entwicklung von Miliartuberkeln gekennzeichnet, kleinen Knötchen, die aus infizierten Makrophagen und granulomatösen Entzündungen bestehen und sich über die betroffenen Organe ausbreiten.
● Klinische Manifestationen: Im Verlauf der Erkrankung können verschiedene Symptome auftreten, darunter Fieber, Gewichtsverlust, Nachtschweiß, Müdigkeit und Atemwegsbeschwerden. Die spezifischen Symptome können je nach den betroffenen Organen und dem Ausmaß der Ausbreitung variieren.
Prognose:
Die Prognose der Miliartuberkulose hängt von mehreren Faktoren ab, darunter der allgemeine Gesundheitszustand des Patienten, das Ausmaß der Organbeteiligung, das Vorliegen von Grunderkrankungen und die Schnelligkeit der Diagnose und des Behandlungsbeginns.
Im Allgemeinen verbessern eine frühzeitige Diagnose und eine angemessene Behandlung die Prognose erheblich. Bei rechtzeitiger und wirksamer Behandlung können viele Patienten mit Miliartuberkulose eine vollständige Heilung der Infektion und Genesung erreichen. In schweren Fällen oder bei Verzögerungen bei der Diagnose und Behandlung können jedoch Komplikationen auftreten, die zu einer schlechteren Prognose führen.
Zu den Komplikationen der Miliartuberkulose können Organfunktionsstörungen wie Leber- oder Nierenversagen, eine Beteiligung des Zentralnervensystems mit Folge einer Meningitis, Atemwegsprobleme und eine disseminierte intravasale Gerinnung (DIC) gehören. Diese Komplikationen können die Prognose erheblich beeinträchtigen und intensive medizinische Maßnahmen erforderlich machen.
Es ist wichtig zu beachten, dass die Prognose von Patient zu Patient variieren kann und eine engmaschige Überwachung des klinischen Ansprechens des Patienten auf die Behandlung für die Beurteilung des Langzeitergebnisses unerlässlich ist. Regelmäßige Nachuntersuchungen und die Einhaltung der verschriebenen Behandlung sind entscheidend, um eine erfolgreiche Behandlung zu gewährleisten und das Risiko eines Rückfalls zu minimieren.
Prävention
Die Prävention der Miliartuberkulose ist von größter Bedeutung, um die Belastung durch die Krankheit und die damit verbundenen Komplikationen zu verringern. Dieser Abschnitt enthält umfassende Informationen zu verschiedenen Präventionsmethoden, die derzeit angewendet werden. Durch die Umsetzung wirksamer Präventionsmaßnahmen können Einzelpersonen ihr Risiko, an Miliartuberkulose zu erkranken, verringern und die Ausbreitung der Infektion verhindern.
Tuberkulose-Impfung:
Der Bacille Calmette-Guérin (BCG)-Impfstoff ist ein weit verbreiteter Impfstoff zur Vorbeugung von Tuberkulose. Obwohl er in erster Linie gegen Lungentuberkulose gerichtet ist, kann die BCG-Impfung auch einen gewissen Schutz gegen Miliartuberkulose bieten. Die Impfung wird für Personen mit hohem Tuberkulose-Risiko empfohlen, z. B. für Personen, die in Endemiegebieten leben oder im Gesundheitswesen arbeiten.
Früherkennung und Behandlung:
Eine rechtzeitige Diagnose und Behandlung der aktiven Tuberkulose und der latenten Tuberkuloseinfektion (LTBI) kann die Entwicklung einer Miliartuberkulose verhindern. Personen mit Verdacht auf Tuberkulose sollten umgehend einen Arzt aufsuchen, und Gesundheitsdienstleister sollten geeignete diagnostische Tests durchführen und unverzüglich mit der Behandlung beginnen.
Maßnahmen zur Infektionskontrolle:
Angemessene Maßnahmen zur Infektionskontrolle spielen eine entscheidende Rolle bei der Verhinderung der Übertragung von Tuberkulose, einschließlich Miliartuberkulose. Gesundheitseinrichtungen sollten sich an die Richtlinien zur Infektionskontrolle halten, darunter eine angemessene Belüftung, die Verwendung von Atemschutzgeräten und die Umsetzung von Isolationsprotokollen für Personen mit aktiver Tuberkulose.
Kontaktverfolgung und Screening:
Die Identifizierung von Personen, die in engem Kontakt mit bestätigten Tuberkulosefällen standen, ist für die Früherkennung und Prävention von Miliartuberkulose von entscheidender Bedeutung. Die Kontaktverfolgung umfasst die Identifizierung und Untersuchung von Personen, die möglicherweise mit Tuberkulose in Kontakt gekommen sind, um latente Infektionen zu erkennen und eine geeignete Behandlung einzuleiten, um das Fortschreiten der Krankheit zu verhindern.
Sicherer Umgang mit Tuberkulosefällen:
Gesundheitsdienstleister und Personen, die Tuberkulosepatienten betreuen, sollten geeignete Maßnahmen zur Infektionskontrolle befolgen, darunter das Tragen von persönlicher Schutzausrüstung und die Einhaltung einer guten Atemhygiene. Dadurch wird das Risiko einer Ansteckung und Übertragung der Infektion verringert.
Aufklärung und Sensibilisierung:
Die Sensibilisierung der Öffentlichkeit für Tuberkulose, ihre Übertragungswege und Präventionsmaßnahmen ist für die Vorbeugung der Krankheit von entscheidender Bedeutung. Aufklärungskampagnen, die Verbreitung von Informationen durch Gesundheitseinrichtungen und Gemeinschaftsorganisationen sowie gezielte Maßnahmen in Hochrisikogruppen können dazu beitragen, das Bewusstsein zu schärfen und präventives Verhalten zu fördern.
Berücksichtigung sozioökonomischer Faktoren:
Sozioökonomische Faktoren wie Armut, Überbelegung und unzureichender Zugang zu Gesundheitsversorgung tragen zum Risiko der Übertragung von Tuberkulose, einschließlich Miliartuberkulose, bei. Die Bekämpfung dieser Faktoren durch verbesserte Lebensbedingungen, Zugang zu Gesundheitsdiensten und Strategien zur Armutsbekämpfung kann dazu beitragen, die Ausbreitung der Krankheit zu verhindern.
Es ist wichtig zu beachten, dass sich die Präventionsmethoden für die Miliartuberkulose weitgehend mit den allgemeinen Strategien zur Tuberkuloseprävention überschneiden.
Zusammenfassung
Die Miliartuberkulose ist eine schwere Form der Tuberkulose, die mehrere Organe befällt und lebensbedrohlich sein kann, wenn sie nicht rechtzeitig diagnostiziert und behandelt wird. Auf dieser medizinischen Informationsseite haben wir die Definition, Arten, Symptome, Komplikationen, Diagnostik, Behandlung, Ursachen, Risikofaktoren und Präventionsmethoden für Miliartuberkulose erläutert. Miliartuberkulose wird durch die Ausbreitung von Mycobacterium tuberculosis-Bakterien im gesamten Körper über den Blutkreislauf verursacht. Die Krankheit kann mit einer Vielzahl von Symptomen einhergehen, darunter Fieber, Gewichtsverlust, Husten und organspezifische Manifestationen. Komplikationen können aufgrund von Organfunktionsstörungen und der Schwere der Infektion auftreten. Die Diagnose umfasst eine Kombination aus klinischer Untersuchung, Labortests und bildgebenden Untersuchungen. Die rechtzeitige Einleitung einer geeigneten Behandlung mit mehreren Tuberkulose-Medikamenten ist entscheidend für einen erfolgreichen Behandlungsverlauf. Zu den Präventionsmaßnahmen gehören Impfungen, die Früherkennung und Behandlung von Tuberkulose, Infektionskontrollmaßnahmen, die Rückverfolgung von Kontakten, der sichere Umgang mit Tuberkulosefällen, Aufklärung und die Berücksichtigung sozioökonomischer Faktoren.